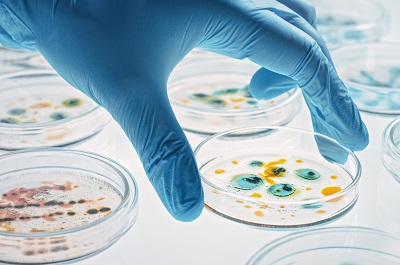

脚气长时间不注意就容易引起肌肤损伤,影响到生活质量,严重的还会诱发全身性的并发症,那么治疗脚气的特效药是什么呢?脚气其实最怕三种药品,下面带大家一起了解一下。
一、治疗脚气的特效药
脚气是有真菌感染引起的皮肤类疾病,传染性还是很强的,如果不注意就很容易影响到正常生活,可以外用或者是口服一些抗真菌的药物治疗脚气,目前来说抗真菌药物有很多,比如咪唑类的药物,丙烯胺类的药物等,以及常见的盐酸特比萘芬片,但是也需要注意在医生指导下服用药物,不可自行盲目服用。
二、脚气最怕三种药品
1、咪唑类的药物
比如常见的硝酸咪康唑乳膏,硝酸益康唑乳膏,硝酸舍他康唑乳膏等,硝酸益康唑乳膏是一种可以抗真菌的药物,涂抹之后可以很好的抑制真菌,杀灭致病菌,针对常见的轻中度脚气有很好的改善。
2、丙烯胺类的药物
丙烯胺类的药物比如盐酸特比萘芬乳膏,盐酸布替萘酚乳膏等,盐酸布替萘酚乳膏是一种皮肤外用的药物,主要是根据个人的情况来选择使用,可以抑制真菌细胞膜的合成来抑制脚气。
3、其他抗真菌乳膏
以盐酸阿莫罗芬乳膏为例,这是一种可以抑制或杀灭常见致病真菌的乳膏,可以缓解脚气引起的肌肤瘙痒,脱屑等情况,针对常见的脚气,体癣等也有作用,另外也可以用抑菌喷剂来每天喷涂减轻脚气,有不错的抑菌杀菌效果。
脚气是一种传染性很强的疾病,在使用这些药物的时候一定要根据个人的情况来用,不可自行盲目使用引起不适,另外还需要注意不能直接用于破损、糜烂或者是炎症肌肤,以免加重病情。
本文来自投稿,不代表金塔网立场,如若转载,请注明出处:https://www.jtagf.com/show_8622.html

微信扫一扫